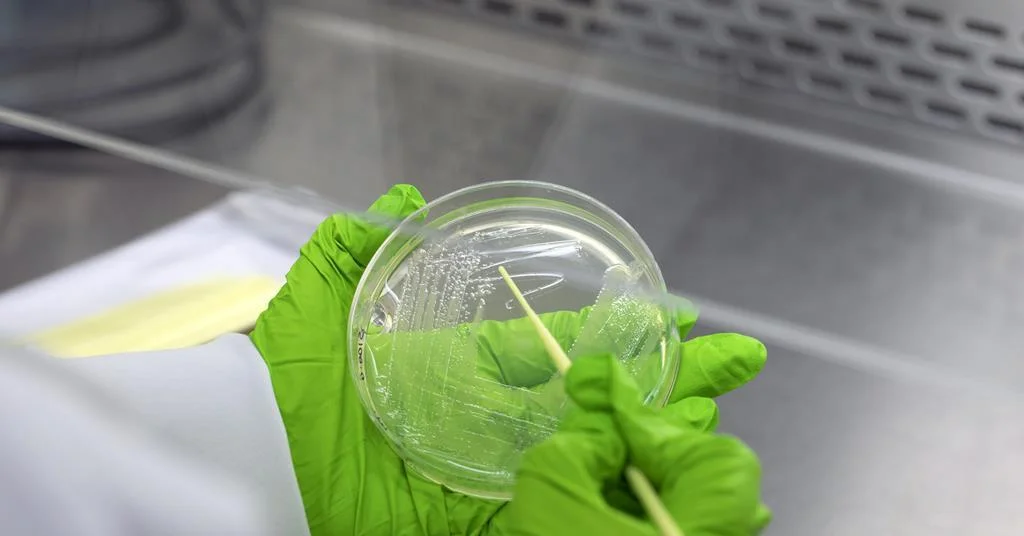
Antimicrobial resistance: Charles Darwin was right; India’s drug policy isn’t - 1

The escalating crisis of antimicrobial resistance (AMR) in India presents a multifaceted public health challenge, deeply intertwined with the country's extensive use and production of antibiotics. While India has acknowledged the complexity of AMR through initiatives like the ‘One Health’ framework, the sheer scale of the problem, driven by factors including over-prescription and inadequate regulation, continues to fuel the rise of drug-resistant bacteria. The implications extend beyond national borders, as India is considered a significant epicenter for the global spread of these "superbugs."
The Evolutionary Nature of Resistance
Antibiotics, while vital for treating infections, act as evolutionary forces. When microbes are exposed to these drugs, they adapt. This adaptation leads to the development of resistance, a phenomenon that Charles Darwin’s theories of evolution help to explain. Just as species evolve over time to adapt to their environments, bacteria evolve to survive the presence of antibiotics.
Read More: Cannabis Prescriptions Rise, Doctors Warn of Psychosis Risk in UK

This resistance is not an anomaly but a logical outcome of widespread antibiotic use.
Environmental reservoirs of resistance genes are created when antibiotic residues enter water bodies.
This perspective highlights that resistance is an intrinsic part of the antibiotic era, rather than an unexpected side effect.
Contributing Factors to India's AMR Crisis
India faces a particularly acute problem with antimicrobial resistance. Several interconnected factors contribute to this growing crisis:

High Burden of Infectious Diseases: India has the highest burden of bacterial infections globally, leading to substantial antibiotic consumption.
Unregulated Antibiotic Consumption: The consumption of antibiotics in India is massive and, in many cases, unregulated.
Over-prescription and Self-Medication: Doctors are sometimes tempted to prescribe antibiotics liberally to treat patients, and self-medication is also prevalent, further contributing to overuse.
Regulatory Gaps: Existing regulatory frameworks have not kept pace with the challenges of antibiotic misuse.
Pharmaceutical Pollution: India is the world's largest producer of antibiotics, and pharmaceutical pollution from manufacturing sites remains largely unregulated, contributing to environmental resistance.
Antibiotic Use in Agriculture: The use of antibiotics in farming practices also plays a role in the spread of resistance.
“You know, they are our clients. So, to start antibiotics, to stop antibiotics, which antibiotics? You’re trained with antibiotic stewardship. They listen to me and they do what I say. If you really want to save the patient, you are tempted to kind of start on the high end [antibiotics] when they come in.”— From "Antimicrobial Resistance, Politics, and Practice in India"
India's Strategic Response: The "One Health" Approach
Recognizing the complex nature of AMR, India has adopted a comprehensive approach known as the ‘One Health’ framework. This strategy acknowledges that the health of humans, animals, and the environment are interconnected and must be addressed collectively to combat antimicrobial resistance.

National Action Plan: India's National Action Plan on Antimicrobial Resistance correctly identifies this complexity.
Coordinated Action: Addressing the crisis requires coordinated efforts across human, animal, and environmental health sectors.
Specific Initiatives: Programs like Kerala's PROUD/AMRITH initiatives are examples of localized efforts within this broader strategy.
Policy Measures and Challenges
India has implemented policies aimed at curbing the misuse of antibiotics. The Red Line campaign, which mandates that prescription-only antibiotics be marked with a red line, is one such initiative designed to discourage over-the-counter sales. However, the effectiveness of these measures is challenged by the pervasive issues of overuse and the speed at which bacteria develop resistance, a timescale that often outpaces governance.
The Red Line campaign aims to control the non-prescription sale of antibiotics.
Despite policy steps, the problem of unnecessary antibiotic prescriptions persists.
The Global Ramifications
India is considered a significant contributor to the global AMR crisis, with research indicating it as a likely birthplace for highly drug-resistant pathogens that have spread worldwide. The epicenters of antibiotic resistance in animals have been identified in India and China.
Read More: Tata Consumer Products Stock: Analysts Say Buy Despite High Price
Bacteria in India have developed resistance to many antibiotics currently available.
This resistance has a global impact, as pathogens can spread internationally.
The Role of Drug Development
While facing challenges, India is also at the forefront of developing new antibiotics to combat resistant strains. Companies are testing novel drugs, such as Wockhardt's Zaynich, aimed at treating severe drug-resistant infections.
New antibiotics are being developed locally to address the growing threat of superbugs.
These locally developed drugs show promise in fighting antibiotic-resistant pathogens.
Expert Perspectives and Analytical Insights
The phenomenon of AMR in India is seen as multifactorial, emerging from the intersection of industrial pharmaceutical development, healthcare access dynamics, policy frameworks, and local practices.
Resistance is not reducible to singular problems of control or regulation but is enacted through cultural and local practices.
Healthcare professionals face pressures that can influence their prescribing habits.
Conclusion and Future Directions
India's battle against antimicrobial resistance is an ongoing and complex endeavor. The nation's commitment to the ‘One Health’ framework is a critical step, but the continued prevalence of factors like over-prescription, self-medication, and inadequate environmental regulation poses significant hurdles. The evolutionary nature of bacterial resistance means that a dynamic and adaptable approach is required.
Findings: India faces a severe AMR crisis driven by widespread antibiotic use and production, coupled with regulatory gaps. The country's strategic adoption of the 'One Health' approach is a positive step, but implementation challenges persist. India's role as an epicenter for AMR has global implications.
Implications: The escalating AMR crisis threatens public health gains and economic development in India and worldwide. The spread of resistant pathogens necessitates robust global cooperation.
Next Steps: Continued strengthening of regulatory oversight, enhanced public awareness campaigns regarding antibiotic stewardship, and further investment in surveillance and new drug development are crucial. Addressing pharmaceutical pollution and antibiotic use in agriculture are also key priorities.
Sources Used:
The Hindu: Antimicrobial resistance: Charles Darwin was right; India’s drug policy isn’t - https://www.thehindu.com/sci-tech/science/darwin-day-antimicrobial-resistance-adaptation-india-drug-policy/article70607352.ece
Drishti IAS: India’s Battle Against Antimicrobial Resistance - https://www.drishtiias.com/daily-updates/daily-news-editorials/indias-battle-against-antimicrobial-resistance
World Economic Forum: This is how India is fighting antimicrobial resistance - https://www.weforum.org/stories/2018/03/india-s-war-on-antimicrobial-resistance/
Chemistry World: Poor antibiotic stewardship blamed as India found to be superbug’s birthplace - https://www.chemistryworld.com/news/poor-antibiotic-stewardship-blamed-as-india-found-to-be-superbugs-birthplace/4010954.article
PLOS Medicine: Antibiotic Resistance in India: Drivers and Opportunities for Action - https://journals.plos.org/plosmedicine/article?id=10.1371/journal.pmed.1001974
GARDP: Over-prescription, self-medication, and regulatory gaps leading causes of antimicrobial resistance in India - https://gardp.org/over-prescription-self-medication-and-regulatory-gaps-leading-causes-of-antimicrobial-resistance-in-india/
BBC News: India's 'blockbuster' drugs to combat antibiotic-resistant superbugs - https://www.bbc.com/news/articles/c80vrjkkrero
Nature: Why India is a stronghold for superbugs - https://www.nature.com/articles/d44151-024-00167-8
PubMed: Antimicrobial Resistance, Politics, and Practice in India - https://pubmed.ncbi.nlm.nih.gov/32458726/ (This links to a study that includes broader context from SAGE Publications).